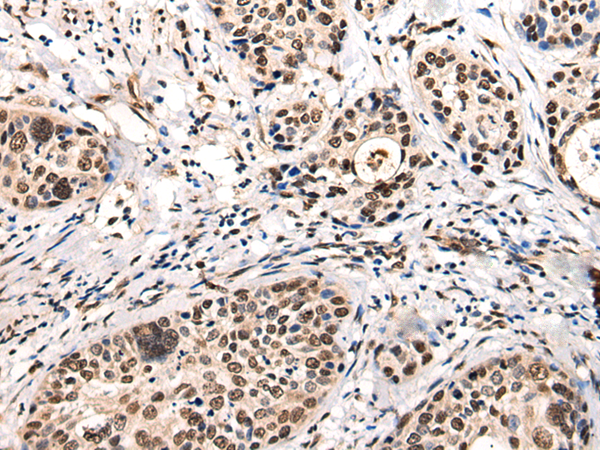

Background:
Acts as a GTPase-activating protein for RAB5A. Involved in receptor trafficking. In complex with EPS8 inhibits internalization of EGFR.
Applications:
ELISA, WB, IHC
Name of antibody:
USP6NL
Immunogen:
Fusion protein of human USP6NL
Full name:
USP6 N-terminal like
Synonyms:
RNTRE; TRE2NL; USP6NL-IT1
SwissProt:
Q92738
ELISA Recommended dilution:
5000-10000
IHC positive control:
Human cervical cancer
IHC Recommend dilution:
25-100
WB Predicted band size:
94 kDa
WB Positive control:
293T cell lysate
WB Recommended dilution:
500-2000

購物車
幫助
021-54845833/15800441009
